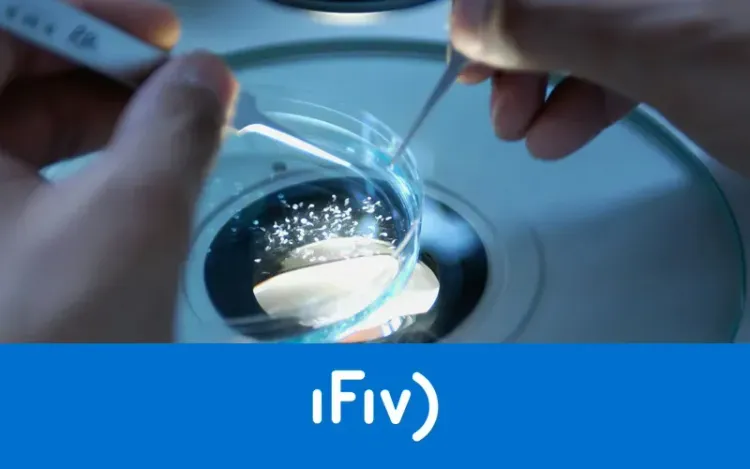
iFiv - La app móvil del laboratorio de IVI

iFiv - La app móvil del laboratorio de IVI
La Aplicación iFiv es un sistema móvil basado en tecnología multiplataforma para el seguimiento y captura de datos en procesos de laboratorio en las clínicas de IVI.
Visitar web →Características principales
El personal del laboratorio de IVI realiza su trabajo en un entorno mucho más exigente que un puesto de oficina habitual, y en el que no se pueden permitir el acceso a un equipo de escritorio. De este modo, tanto el acceso a la información de trabajo como la toma de datos de laboratorio se realizaba en papel. Estos datos debían ser luego introducidos en el sistema de gestión manualmente.
vBote desarrolló una solución móvil integrada con el sistema de gestión de IVI que permite al personal de laboratorio consultar e introducir los nuevos resultados de sus pruebas en un dispositivo Tablet:
- Los datos recopilados en el dispositivo móvil se incorporan automáticamente al sistema de gestión de IVI, ahorrando tareas duplicadas y consiguiendo que la información esté disponible al instante.
- Los datos de resultados anteriores están disponibles en tiempo real en el propio laboratorio, por lo que la toma de decisiones es mucho más efectiva y redunda en una mejora global de la calidad del proceso.
Adicionalmente, se incorporaron funciones auxiliares para la planificación de clínica, de manera que los datos sobre las citas y su calendario son accesibles en movilidad: los usuarios pueden consultar información de los pacientes de forma cómoda desde cualquier lugar para preparar las consultas y realizar su trabajo con mayor eficiencia.
Resultados obtenidos
La solución iFiv para dispositivos móviles implantada por IVI de la mano de vBote elimina las tareas manuales de captura de información en laboratorio, facilita la toma de decisiones, y mejora la planificación de clínica.
IVI es la primera institución médica dedicada íntegramente a la reproducción asistida humana. Hoy es uno de los mayores grupos en medicina reproductiva en el mundo y cuenta con un total de 23 clínicas en 7 países. Desde sus inicios ya son más de 55.000 niños los que han nacido gracias a las técnicas más vanguardistas de reproducción asistida que se practican en las clínicas IVI.